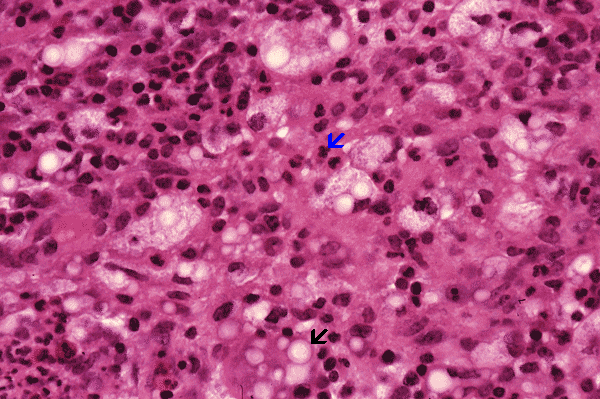

April 2003, Case 304-2.
|
This is a medium-magnification photo taken from the same area. The polymorphonuclear leukocytes can be well appreciated (ß). The bubbly cells that are seen at low-magnification appeared to be cells containing round organisms with thick and pale stining wall (ß); many of these cells also have foamy cytoplasm and they are most likely macrophages. |